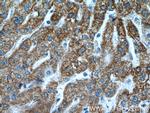
SUOX Antibody in Immunohistochemistry (Paraffin) (IHC (P))

Search
Proteintech
SUOX Polyclonal Antibody
{{$productOrderCtrl.translations['antibody.pdp.commerceCard.promotion.promotions']}}
{{$productOrderCtrl.translations['antibody.pdp.commerceCard.promotion.viewpromo']}}
{{$productOrderCtrl.translations['antibody.pdp.commerceCard.promotion.promocode']}}: {{promo.promoCode}} {{promo.promoTitle}} {{promo.promoDescription}}. {{$productOrderCtrl.translations['antibody.pdp.commerceCard.promotion.learnmore']}}
产品信息
15075-1-AP
种属反应
已发表种属
宿主/亚型
分类
类型
抗原
偶联物
形式
浓度
规格
纯化类型
保存液
内含物
保存条件
运输条件
产品详细信息
Immunogen sequence: RHPALKVNS QRPFNAEPPP ELLTENYITP NPIFFTRNHL PVPNLDPDTY RLHVVGAPGG QSLSLSLDDL HNFPRYEITV TLQCAGNRRS EMTQVKEVKG LEWRTGAIST ARWAGARLCD VLAQAGHQLC ETEAHVCFEG LDSDPTGTAY GASIPLARAM DPEAEVLLAY EMNGQPLPRD HGFPVRVVVP GVVGARHVKW LGRVSVQPEE SYSHWQRRDY KGFSPSVDWE TVDFDSAPSI QELPVQSAIT EPRDGETVES GEVTIKGYAW SGGGRAVIRV DVSLDGGLTW QVAKLDGEEQ RPRKAWAWRL WQLKAPVPAG QKELNIVCKA VDDGYNVQPD TVAPIWNLRG VLSNAWHRVH VYVSP (182-545 aa encoded by BC065193)
靶标信息
Sulfite oxidase is a homodimeric protein localized to the intermembrane space of mitochondria. Each subunit contains a heme domain and a molybdopterin-binding domain. The enzyme catalyzes the oxidation of sulfite to sulfate, the final reaction in the oxidative degradation of the sulfur amino acids cysteine and methionine. Sulfite oxidase deficiency results in neurological abnormalities which are often fatal at an early age. Alternative splicing results in multiple transcript variants encoding identical proteins.
仅用于科研。不用于诊断过程。未经明确授权不得转售。
生物信息学
蛋白别名: Sulfite oxidase, mitochondrial; unnamed protein product
基因别名: SO; SUOX
UniProt ID: (Human) P51687, (Mouse) Q8R086, (Rat) Q07116
Entrez Gene ID: (Human) 6821, (Mouse) 211389, (Rat) 81805